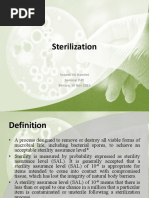

Introduction Sterilization can be defined as any process that effectively kills or eliminates transmissible agents (such as fungi, bacteria,
viruses and prions) from a surface, equipment, foods, medications, or biological culture medium. In practice sterility is achieved by exposure of the ob ect to be sterilized to chemical or physical agent for a specified time. !arious agents used as steriliants are" elevated temperature, ionizing radiation, chemical liquids or gases etc. #he success of the process depends upon the choice of the method adopted for sterilization. Pharmaceutical Importance of Sterilization $% &oist heat sterilization is the most efficient biocidal agent. In the pharmaceutical industry it is used for" Surgical dressings, Sheets, Surgical and diagnostic equipment, 'ontainers, 'losures, (queous in ections, )phthalmic preparations and Irrigation fluids etc. *% +ry heat sterilization can only be used for thermo stable, moisture sensitive or moisture impermeable pharmaceutical and medicinal. #hese include products like, +ry po-dered drugs, Suspensions of drug in non aqueous solvents, )ils, fats -axes, soft hard paraffin silicone, )ily in ections, implants, ophthalmic ointments and ointment bases etc. .% /aseous sterilization is used for sterilizing thermolabile substances like, hormones, proteins, various heat sensitive drugs etc. 0% 1.! light is perhaps the most lethal component in ordinary sunlight used in sanitation of garments or utensils. 2% /amma3rays from 'obalt 45 are used to sterilize antibiotic, hormones, sutures, plastics and catheters etc. 4% 6iltration sterilizations are used in the treatment of heat sensitive in ections and ophthalmic solutions, biological products, air and other gases for supply to aseptic areas. #hey are also used in industry as part of the venting systems on fermentors, centrifuges, autoclaves and freeze driers. &embrane filters are used for sterility testing. !ariables that affect sterilization include" $. #he dryness of devices to be processed *. #he temperature and humidity of the processing area .. 7hether or not the devices -ere properly prepared and loaded into the sterilizer 0. 7hether or not the sterilizing agent is properly delivered into the system 2. #he sterilizer8s condition and maintenance protocol 4. 7hether or not the correct sterilization method and cycle -ere used Terms commonly used Survivor curves #hey are plots of the logarithm of the fraction of survivors (microorganisms -hich retain
�viability follo-ing a sterilization process) against the exposure time or dose.
�Expression of resistance D-value +3value is indicative of the resistance of any organism to a sterilizing agent. 6or radiation and heat treatment, +3value is the time taken at a fixed temperature or the radiation dose required to achieve a 95: reduction in viable count. Z-value ;3value represents the increase in temperature needed to reduce the +3value of an organism by 95:. Methods of Sterilization #he various methods of sterilization are" $. <hysical ðod $. #hermal (=eat) methods *. >adiation method .. 6iltration method 'hemical ðod $. /aseous method
*.
$. Heat Sterilization =eat sterilization is the most -idely used and reliable method of sterilization, involving destruction of enzymes and other essential cell constituents. #he process is more effective in hydrated state -here under conditions of high humidity, hydrolysis and denaturation occur, thus lo-er heat input is required. 1nder dry state, oxidative changes take place, and higher heat input is required. #his method of sterilization can be applied only to the thermostable products, but it can be used 5 for moisture3sensitive materials for -hich dry heat ($453$?5 ') sterilization, and for moisture3 resistant materials for -hich moist heat ($*$3$.05') sterilization is used. #he efficiency -ith -hich heat is able to inactivate microorganisms is dependent upon the degree of heat, the exposure time and the presence of -ater. #he action of heat -ill be due to induction of lethal chemical events mediated through the action of -ater and oxygen. In the presence of -ater much lo-er temperature time exposures are required to kill microbe than in the absence of -ater. In this processes both dry and moist heat are used for sterilization. a. Dry Heat Sterilization @xamples of +ry heat sterilization are" $. Incineration *. >ed heat .. 6laming 0. =ot air oven It employs higher temperatures in the range of $453$?55' and requires exposures time up to * hours, depending upon the temperature employed. #he benefit of dry heat includes good penetrability and non3corrosive nature -hich makes it applicable for sterilizing glass-ares and
�metal surgical instruments. It is also used for sterilizing non3aqueous thermostable liquids and thermostable po-ders. +ry heat destroys bacterial endotoxins (or pyrogens) -hich are difficult to eliminate by other means and this property makes it applicable for sterilizing glass bottles -hich are to be filled aseptically. Hot-air oven +ry heat sterilization is usually carried out in a hot air oven, -hich consists of the follo-ing" $) *) .) 0) 2) 4) !peration $) *) .) 0) (rticles to be sterilized are first -rapped or enclosed in containers of cardboard, paper or aluminum. #hen, the materials are arranged to ensure uninterrupted air flo-. )ven may be pre3heated for materials -ith poor heat conductivity. 5 #he temperature is allo-ed to fall to 05 ', prior to removal of sterilized material. (n insulated chamber surrounded by an outer case containing electric heaters. ( fan Shelves #hermocouples #emperature sensor +oor locking controls.
b.Moist Heat Sterilization &oist heat may be used in three forms to achieve microbial inactivation $. +ry saturated steam A (utoclaving *. Boiling -aterC steam at atmospheric pressure .. =ot -ater belo- boiling point &oist heat sterilization involves the use of steam in the range of $*$3$.0 5'. Steam under pressure is used to generate high temperature needed for sterilization. Saturated steam (steam in thermal equilibrium -ith -ater from -hich it is derived) acts as an effective sterilizing agent. Steam for sterilization can be either -et saturated steam (containing entrained -ater droplets) or dry saturated steam (no entrained -ater droplets). (utoclaves use pressurized steam to destroy microorganisms, and are the most dependable systems available for the decontamination of laboratory -aste and the sterilization of laboratory glass-are, media, and reagents. 6or efficient heat transfer, steam must flush the air out of the autoclave chamber. Before using the autoclave, check the drain screen at the bottom of the chamber and clean if blocked. If the sieve is blocked -ith debris, a layer of air may form at the bottom of the autoclave, preventing efficient operation. (utoclaves should be tested periodically -ith biological indicators like cultures of Bacillus stearothermophilus to ensure proper function. #his method of sterilization -orks -ell for many metal and glass items but is not acceptable for rubber, plastics, and equipment that -ould be damaged by high temperatures (6igure $).
�6ig. $" (n (utoclave (utoclaves, or steam sterilizers essentially consist of follo-ing" $) *) .) 0) 2) 4) ( cylindrical or rectangular chamber, -ith capacities ranging from 055 to ?55 liters. 7ater heating system or steam generating system Steam outlet and inlet valves Single or double doors -ith locking mechanism. #hermometer or temperature gauge <ressure gauges
!peration 6or porous loads (dressings) sterilizers are generally operated at a minimum temperature of
�$.0 ', and for bottled fluid, sterilizers employing a minimum temperature of $*$ ' are used. @nsure that there should be sufficient -ater in the autoclave to produce the steam. #he stages of operation of autoclaves include air removal, steam admission and sterilization cycle (includes heating up, holdingCexposure, and cooling stages). "aseous Sterilization #he chemically reactive gases such as formaldehyde, (methanol, =.'=)) and ethylene oxide ('=*)*) possess biocidal activity. @thylene oxide is a colorless, odorless, and flammable gas. #he mechanism of antimicrobial action of the t-o gases is assumed to be through alkylations of sulphydryl, amino, hydroxyl and carboxyl groups on proteins and amino groups of nucleic acids. #he concentration ranges (-eight of gas per unit chamber volume) are usually in range of ?553 $*55 mgCD for ethylene oxide and $23$55 mgCD for formaldehyde -ith operating temperatures of 0234.E' and F53F2E' respectively. Both of these gases being alkylating agents are potentially mutagenic and carcinogenic. #hey also produce acute toxicity including irritation of the skin, con unctiva and nasal mucosa.
�a# Ethylene oxide sterilizer (n ethylene oxide sterilizer consists of a chamber of $553.553Ditre capacity and surrounded by a -ater acket. (ir is removed from sterilizer by evacuation, humidification and conditioning of the load is done by passing sub3atmospheric pressure steam, then evacuation is done again and preheated vaporized ethylene oxide is passed. (fter treatment, the gases are evacuated either directly to the outside atmosphere or through a special exhaust system. @thylene oxide gas has been used -idely to process heat3sensitive devices, but the aeration times needed at the end of the cycle to eliminate the gas made this method slo-. $# %o& temperature steam formaldehyde '%TS() sterilizer (n D#S6 sterilizer operates -ith sub atmospheric pressure steam. (t first, air is removed by evacuation and steam is admitted to the chamber. %i*uid Sterilization a# Peracetic +cid li*uid sterilization <eracetic acid -as found to be sporicidal at loconcentrations. It -as also found to be -ater soluble, and left no residue after rinsing. It -as also sho-n to have no harmful health or environmental effects. It disrupts bonds in proteins and enzymes and may also interfere -ith cell membrane transportation through the rupture of cell -alls and may oxidize essential enzymes and impair vital biochemical path-ays. In a lo-3temperature liquid chemical sterile processing system, several steps must be follo-ed for effective sterilization" $. <re3cleaning of the devices is necessary because many devices have small connected lumens. *. Deak testing is done to ensure there are no leaks that could allo- fluid to enterCleak the ampoulesCvials and cause damage. .. #he appropriate trayCcontainer must then be selected, and if the device has lumens, the appropriate connector attached. 0. #he sterilant concentrate is provided in a sealed single3 use cup and requires no pre3mixing or dilution. #he disadvantages of this method of sterilization are that the devices must be immersible, must fit in the appropriate tray, and must be able to -ithstand the 22E' temperature the process uses. $# Hydro,en Peroxide Sterilization #his method disperses a hydrogen peroxide solution in a vacuum chamber, creating a plasma cloud. #his agent sterilizes by oxidizing key cellular components, -hich inactivates the microorganisms. #he plasma cloud exists only -hile the energy source is turned on. 7hen the energy source is turned off, -ater vapor and oxygen are formed, resulting in no toxic residues and harmful emissions. #he temperature of this sterilization method is maintained in the 05325E' range, -hich makes it particularly -ell3suited for use -ith heat3sensitive and moisture3sensitive medical devices. #he instruments are -rapped prior to sterilization, and can either be stored or used immediately.
�#here are five phases of the hydrogen peroxide processing cycle" $. ( vacuum phase creates a vacuum in the chamber and the pressure drops to less than one pound per square inch. #his phase lasts about *5 minutes. *. In the in ection phase, the aqueous hydrogen peroxide is introduced into the vacuum chamber and is vaporized into a gas, -hich creates a rise in pressure due to the increase of molecules. .. +uring the diffusion phase the hydrogen peroxide vapor spreads throughout the chamber and the increased pressure drives the sterilant into the packs, exposing the instrument surfaces to the sterilant and killing the microorganisms. 0. +uring the plasma phase the radio frequency energy is applied, stripping the electrons from some of the molecules and producing a lo-3temperature plasma cloud. 6ollo-ing this reaction, the activated compounds lose their high energy and recombine to form oxygen and -ater. 2. #he purpose of the venting phase is to introduce filtered air into the chamber and return the chamber to atmospheric pressure so that the door can be opened. It lasts about one minute. -adiation Sterilization &any types of radiation are used for sterilization like electromagnetic radiation (e.g. gamma rays and 1! light), particulate radiation (e.g. accelerated electrons) .#he ma or target for these radiation is microbial +G(. /amma rays and electrons cause ionization and free radical production -hile 1! light causes excitation. >adiation sterilization -ith high energy gamma rays or accelerated electrons has proven to be a useful method for the industrial sterilization of heat sensitive products. But some undesirable changes occur in irradiated products, an example is aqueous solution -here radiolysis of -ater occurs. >adiation sterilization is generally applied to articles in the dry state, including surgical instruments, sutures, prostheses, unit dose ointments, plastic syringes and dry pharmaceutical products. 1! light, -ith its much lo-er energy, and poor penetrability finds uses in the sterilization of air, for surface sterilization of aseptic -ork areas, for treatment of manufacturing grade -ater, but is not suitable for sterilization of pharmaceutical dosage forms. a# "amma ray Sterilizer /amma rays for sterilization are usually derived from cobalt345 source, the isotope is held as pellets packed in metal rods, each rod carefully arranged -ithin the source and containing *5 H'i of activity. #his source is housed -ithin a reinforced concrete building -ith * m thick -alls. (rticles being sterilized are passed through the irradiation chamber on a conveyor belt and move around the raised source. .ltraviolet Irradiation #he optimum -avelength for 1! sterilization is *45 nm. ( mercury lamp giving peak emission at *20 nm is the suitable source of 1! light in this region.
�Electron +ccelerator #here are t-o types of electron accelerator machines, the electrostatic accelerator -hich produces electrons -ith maximum energies of 2 &e!, and the micro-ave linear accelerator -hich produces electrons -ith maximum energies of $5 &e!. =igher energies cause better penetration into the product but there is a risk of induced radiation. ( high energy electron beam is generated by accelerating electrons from a hot filament do-n an evacuated tube under high potential difference, and then additional energy is imparted to this beam in a pulsed manner by a synchronized traveling micro-ave. (rticles to be sterilized are arranged on a horizontal conveyor belt and are irradiated from one or both sides. (iltration Sterilization 6iltration process does not destroy but removes the microorganisms. It is used for both the clarification and sterilization of liquids and gases as it is capable of preventing the passage of both viable and non viable particles. #he ma or mechanisms of filtration are sieving, adsorption and trapping -ithin the matrix of the filter material. Sterilizing grade filters are used in the treatment of heat sensitive in ections and ophthalmic solutions, biological products and air and other gases for supply to aseptic areas. #hey are also used in industry as part of the venting systems on fermentors, centrifuges, autoclaves and freeze driers. &embrane filters are used for sterility testing. +pplication of filtration for sterilization of ,ases =@<( (=igh efficiency particulate air) filters can remove up to 99.9F: of particles I5.. micrometer in diameter. (ir is first passed through prefilters to remove larger particles and then passed through =@<( filters. #he performance of =@<( filter is monitored by pressure differential and airflo- rate measurements. #here are t-o types of filters used in filtration sterilization ($) Depth filters 'onsist of fibrous or granular materials so packed as to form t-isted channels of minute dimensions. #hey are made of diatomaceous earth, unglazed porcelain filter, sintered glass or asbestos. (*) Mem$rane filters #hese are porous membrane about 5.$ mm thick, made of cellulose acetate, cellulose nitrate, polycarbonate, and polyvinylidene fluoride, or some other synthetic material.#he membranes are supported on a frame and held in special holders. 6luids are made to transverse membranes by positive or negative pressure or by centrifugation. +pplication of filtration for sterilization of li*uids &embrane filters of 5.** micrometer nominal pore diameter are generally used, but sintered filters are used for corrosive liquids, viscous fluids and organic solvents. #he factors -hich affects the performance of filter is the titre reduction value, -hich is the ratio of the number of organism challenging the filter under defined conditions to the number of organism penetrating it. #he other factors are the depth of the membrane, its charge and the tortuosity of the channels. #he merits, demerits and applications of different methods of sterilization are given in #able $.
�Ta$le / Merits0 Demerits and +pplications of Different Methods of Sterilization
Methods =eat sterilization Mechanism +estroys bacterial endotoxins Merits &ost -idely used and reliable method of sterilization, involving destruction of enzymes and other essential cell constituents. Demer its 'an be applied only to the thermostable product s +pplication s +ry heat is applicable for sterilizing glass-ares and metal surgical instruments and moi heat is st the most dependable method for decontamination of laboratory -aste and the sterilization of laboratory glass-are, media, and reagents. @thylene oxide gas use has been d -id ely to process heat3 sensitive devices. >adiation sterilization is generally applied to articles in the dry state, including surgical instruments, sutures, prostheses, unit dose
/aseous sterilization
(lkylation
<enetrati ng ability of gases
/ases being alkylati ng agents are potentially mutagenic and carcinogenic 1ndesirable change occu s r in irradiated products,an exampl e is aqueou s solutio -her n e radioly sis of -ater occurs.
>adiation sterilization
Ionization of nucleic acids
It is a useful method for the industrial sterilization of heat sensitive products.
�6iltration sterilization
+oes not destroy but removes the microorganisms
It is used both clarificati on and sterilizati on liquids
fo r th e
+oes not differentiate bet-een viable and non viable particle s
ointments, plastics #his method is Sterilizing grade filters are used in the treatment of heat sensitive in ections and ophthalmic solutions, biological products and air and other gases for supply to aseptic area s.
of an d
gases as it is capable of preventin th g e passage of both viable no and n viable particles.